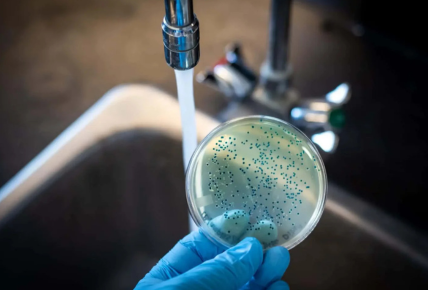
bacteria removal

Understanding L Profiles and L Patti: Versatile Solutions for Modern Construction
In today’s world of architectural finesse and interior detailing, the demand for smart, durable, and aesthetically pleasing construction components is higher than ever. Among these, L profiles — also known in many regions as L Patti — have become indispensable…
Unlocking Performance: Mercedes C63 W205 Catted & Catless Downpipes vs A45S Decat Downpipe
When it comes to performance tuning for high-end Mercedes-Benz vehicles, one of the most impactful upgrades you can make is installing an aftermarket downpipe. Whether you’re driving a thunderous Mercedes C63 W205 or a razor-sharp Mercedes A45S, replacing the restrictive…
Японские аукционы: качество без переплат
Рынок японских автомобилей с пробегом всегда представлял особую ценность для покупателей из России и стран СНГ. Это объясняется строгими правилами эксплуатации в Японии, регулярным обслуживанием и, главное, уникальной аукционной системой, которая обеспечивает максимально объективную оценку состояния каждого автомобиля. Однако самостоятельное…
Securing Your Company through Full-scale Hacking Testing Solutions.
The world appears to be becoming interconnected with other sections of the globe; this has enhanced cyber threats to businesses which have the ability of causing harm to their business. A cyberattack can be catastrophic through ransomware attacks and data…
Simplifying Vehicle Compliance: How to Easily Book Your HSRP on Book My HSRP Com
Are you looking to stay compliant with the latest Indian traffic regulations? Booking your High Security Registration Plate (HSRP) has never been easier. In this guide, we explain how to use book my hsrp to book your number plate quickly,…
Easy Guide to Book My HSRP and Book My HSRP Com Online for Vehicle Owners
In recent years, the Indian government has made High-Security Registration Plates (HSRP) mandatory for all vehicles, new or old. This move aims to standardize vehicle identification, enhance security, and prevent misuse of registration numbers. However, many vehicle owners are still…
Best Social Media Marketing Agencies in Atlanta for Brand Growth
In today’s hyperconnected digital landscape, building a strong brand presence online is no longer optional—it’s essential. For businesses seeking to dominate the Southeast market, partnering with an agency specializing in Social Media Marketing in Atlanta can be a transformative move….
The Rise of Conscious Storytelling: Exploring Environmental and Art Film Festivals
In a world where storytelling shapes awareness, the environmental film festival movement has become a vital part of the global cultural landscape. These festivals showcase powerful narratives that inspire viewers to reflect on their relationship with the planet. Whether through…
Hiring Dedicated Developers: Building Your Ideal Dedicated Development Team
In today’s fast-paced digital world, the demand for highly skilled software developers continues to grow. Whether you are a startup aiming to build a revolutionary app or an established company looking to scale your existing IT capabilities, hiring dedicated developers…
Explore the Wonders of Sundarban with Exclusive Tour Packages
The Sundarbans, a UNESCO World Heritage Site, is one of the most enchanting destinations in India. Nestled in the delta region of the Ganges, Brahmaputra, and Meghna rivers, this unique mangrove forest stretches across West Bengal and Bangladesh. Known for…